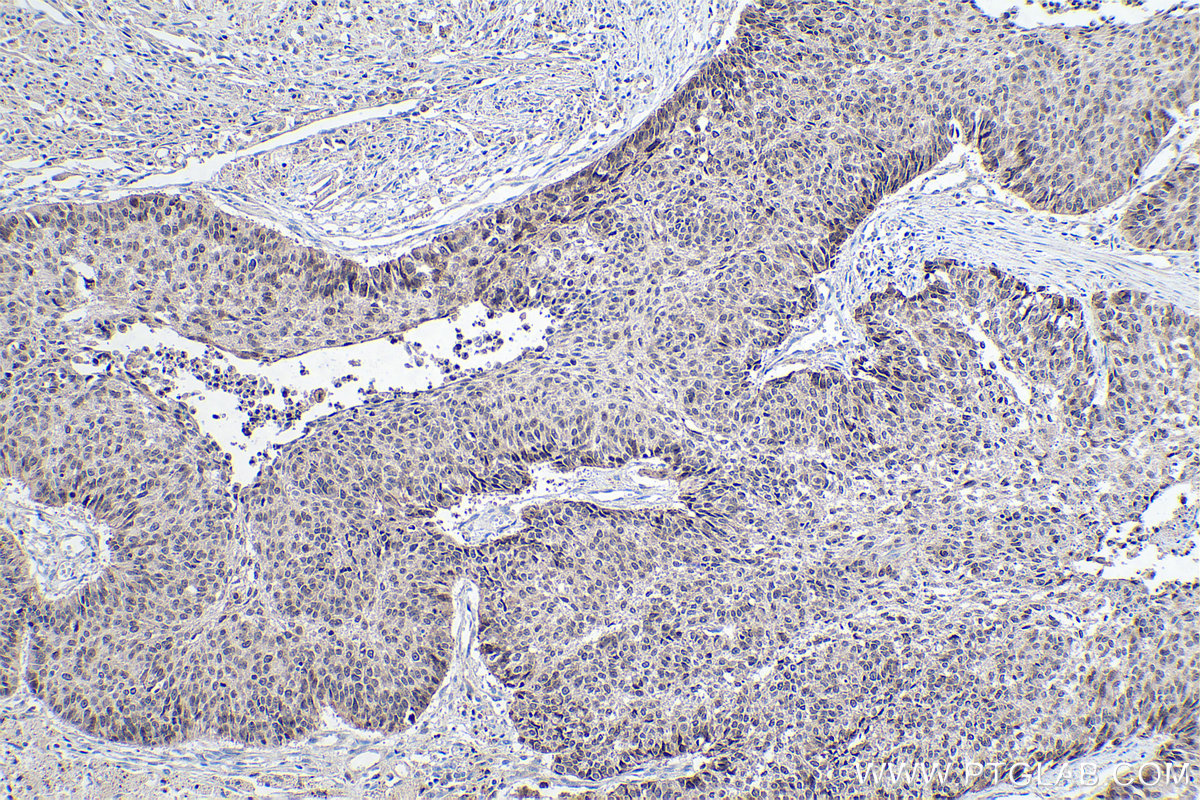

IHCeasy® HMGA2 Ready-To-Use IHC Kit
HMGA2 Ready-to-use reagent kit for IHC.
Reactivity
Human, Mouse, Rat
Sample Type
FFPE tissue
Cat no : KHC0265
Synonyms
BABL, high mobility group AT hook 2, HMGA2, HMGI C, HMGIC, LIPO, STQTL9
Validation Data Gallery
Product Information
KHC0265 is a ready-to-use IHC kit for staining of HMGA2. The kit provides all reagents, from antigen retrieval to cover slip mounting, that require little to no diluting or handling prior to use. Simply apply the reagents to your sample slide according to the protocol and you're steps away from obtaining high-quality IHC data.
| Product name | IHCeasy HMGA2 Ready-To-Use IHC Kit |
| Sample type | FFPE tissue |
| Assay type | Immunohistochemistry |
| Primary antibody type | Rabbit Polyclonal |
| Secondary antibody type | Polymer-HRP-Goat anti-Rabbit |
| Reactivity | Human, Mouse, Rat |
Kit components
| Component | Size | Concentration |
|---|---|---|
| Antigen Retrieval Buffer | 100 mL | 50× |
| Washing Buffer | 100 mL ×2 | 20× |
| Blocking Buffer | 5 mL | RTU |
| Primary Antibody | 5 mL | RTU |
| Secondary Antibody | 5 mL | RTU |
| Chromogen Component A | 0.2 mL | RTU |
| Chromogen Component B | 4 mL | RTU |
| Signal Enhancer | 5 mL | RTU |
| Counter Staining Reagent | 5 mL | RTU |
| Mounting Media | 5 mL | RTU |
| Datasheet | 1 Copy | |
| Manual | 1 Copy |
Background Information
HMGA2 belongs to the family of high mobility group with AT-hook DNA binding domain. HMGA proteins are considered architectural transcription factors; they do not have direct transcriptional activation capacity, but instead regulate gene expression by changing DNA conformation through binding to AT-rich regions in the DNA and/or direct interaction with other transcription factors. HMGA2 is abundantly and ubiquitously expressed and plays a crucial role during embryonic development. HMGA2 promotes stem cell self-renewal and research studies have shown that decreased HMGA2 expression is associated with stem cell aging. Investigators have shown that expression levels of HMGA2 are very low in normal adult tissues, while either overexpression or rearrangement is associated with many types of cancer.
Properties
| Storage Instructions | All the reagents are stored at 2-8°C. The kit is stable for 6 months from the date of receipt. |
| Synonyms | BABL, high mobility group AT hook 2, HMGA2, HMGI C, HMGIC, LIPO, STQTL9 |